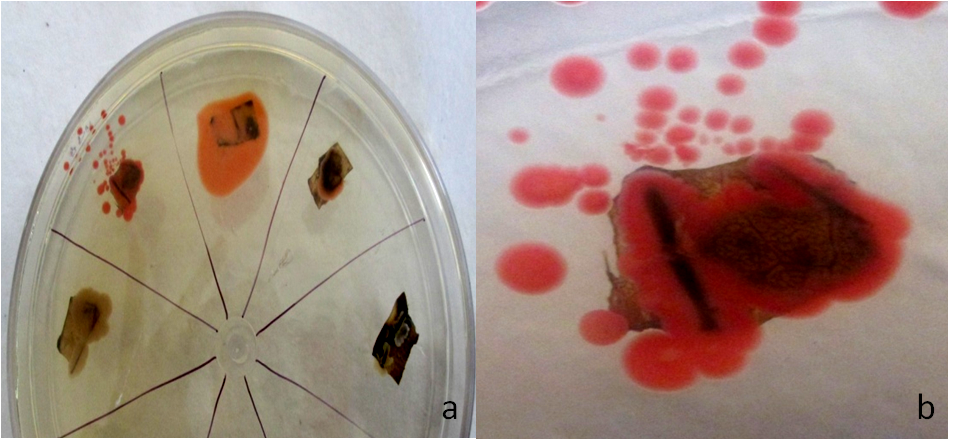

Int J Pharm Pharm Sci, Vol 7, Issue 5, 220-224Original Article
ISOLATION AND IDENTIFICATION OF ENDOPHYTIC BACTERIA PRODUCING BRIGHT RED PIGMENT FROM THE DYE YIELDING PLANT BETA VULGARIS L
BUSHRA KHANAM, RAMESH CHANDRA*
Department of Bioengineering, Birla Institute of Technology, Mesra 835215, Ranchi, Jharkhand, India
Email: rameshchandra@bitmesra.ac.in
Received: 24 Feb 2015 Revised and Accepted: 25 Mar 2015
ABSTRACT
Objectives: Isolation of endophytic bacteria from the of Beta vulgaris L. for production of pigment. Characterization of isolated bacterial endophyte with respect to morphological, biochemical and molecular biological aspects which lead to their identification.
Methods: Plant materials were sterilized by standard methods. Isolation of bacterial endophyte using nutrient media was carried out. Sterility check of explants was performed using two techniques. Morphological, biochemical and molecular biology methods were employed for identification of isolated endophyte. Light microscopy and scanning electron microscopy, molecular gene sequencing was performed on endophytic isolate KC1. Phylogenetic tree was constructed to find the similarity of KC1 and other bacteria.
Results: The isolate KC1 was found acoccobaccilus, gram negative, which gave a catalase positive reaction and after molecular identification, it was designated as Serratiamarcescens strain VIT-PTS (GenBank Accession Number: KJ716445.1)
Conclusion: The results indicate that 17 endophytic bacteria are isolated out of that one bacterial isolate KC1 secretes red pigment. Based on the phylogenetic analysis of 16S rRNA gene sequences, isolate KC1 and Serratiamarcescens were in the same terminal clade. This bacterial pigment, which is expected to be prodigiosin, is promising as potential textile and food colorant.
Keywords: Endophytic bacteria, Beta valgaris L., Identification, Serratiamarcescens, Red pigment.
INTRODUCTION
Endophytes are those microorganisms that inhabit inside of the plants, especially leaves, stems, roots and show no apparent harm to the host [1]. Almost all classes of vascular plants and grasses examined to date are found to host endophytic organisms [2]. Different groups of organisms such as fungi, bacteria, actinomycetes and mycoplasma are reported as endophytes of plant [3]. Endophytes are presumably ubiquitous in plant, which depend on the host species and location and they have been recognized as a valuable source of novel bioactive metabolites [4]. Utilizing microorganisms (especially the fungi) to produce some chemicals and bioactive compounds production by fermentation is highly promising because it could be further enhanced by optimizing the fermentation techniques or meliorating the seed of microorganisms. The endophytes may provide protection and survival conditions to their host plant by producing a plethora of substances which, once isolated and characterized, may also have potential for use in industry, agriculture, and medicine which include carotenoids, flavonoids, anthocyanins and some tetrapyrroles [5].
During last few years, interest in synthetically derived pigments has decreased due to their toxic, carcinogenic, and teratogenic properties and attention towards microbial sources have increased as safe alternatives [6]. Several species of algae, fungi and bacteria have been exploited commercially for the production of pigments [7]. Microbial pigments are of industrial interest because they are often more stable and soluble than those from plant or animal sources [8]. Microorganisms can grow rapidly which can lead to high productivity and can produce a product throughout the year [9]. During last decade, plenty of secondary metabolites from these microorganisms has been tested to have applications as medicinal and agrochemical candidates [10]. Nowadays, the utilization of natural pigments in foodstuff and feedstuff has been increased due to the marketing advantages of employing natural ingredients [11]. Bacterial groups are significant natural-pigment sources because bacterial pigments could easily be produced in high quantity via fermentation technology and potential application of metabolic engineering tools. Many of the endophytic bacterial strains have attracted special attention because they have the capability of producing different colouring pigments with high chemical stability [12]. Bacterial endophyte KC1 isolated from the leaves of Beta vulgaris L. in biochemistry laboratory displayed strong ability to produce red pigment.
In the last few decades, a considerable amount of knowledge has accumulated on the biology of endophytic microorganisms and scientists have focused their study on endophytes. The mutual relationships between entophytic microbes and respective host plants, taxonomy and ecology, etc. of endophytes are being studied. Beet root (Beta vulgaris L.) belongs to the family Chenopodiaceae. Beet root is a biennial plant which has been cultivated in many part of India. It is commonly known as chukandar, beet root or garden beet. The main pigment in the beet root is betanin (red betacynin) along with other pigment yellow betaxanthins; both are water soluble. Bacterial endophyte KC1, isolated from the leaves of Beta vulgaris L. in the present study, we performed the identification of this isolate using morphological and molecular techniques. Morphological examination depended mainly on light microscope and scanning electron microscope (SEM),phylogenetic analysis of 16S rRNA gene sequences was combined with traditional methods.
MATERIALS AND METHODS
Sample collection
The plant material was collected from the various places of Ranchi. For isolation of endophytes, healthy and mature plants of Beta vulgaris L. (13-14 weeks old) were carefully chosen and collected during August 2014. Leaves, roots and stems of selected plants were carefully cut out and packed in sterile zip-lock plastic bags. Collected samples were brought to the laboratory.
Surface sterilization, isolation and culture of the endophytic bacteria
Explants were cleaned under running tap water initially. Samples were surface-sterilized successively with 70% ethanol for 5 min, rinsed with sterile water and then treated with 7-8 drops of tween20 for 10 min for gentle reduction in surface tension and to allow the sterilizing agent to reach into niches and grooves beyond the epidermal cells [13]. This was followed by sequential immersion of each plant parts in 2% bavistin solution for 10 min and then in 0.1% HgCl2 for 10 min under laminar air flow chamber. To remove the disinfectants explants were rinsed three to four times with sterilized distilled water then blotted into autoclaved tissue paper [14]. The surface sterilized explants were cut into approximate 0.5 x 1x 0.5 cm pieces using a sterile blade and placed on nutrient agar petri-dishes [15]. The plates with explants were sealed using paraffin and incubated at 28± °C in order to recover the maximum possible entophytes. The observation is recorded after six to seven days. After a few days the bacterial cultures were repeatedly streaked in order to achieve pure endophytic isolates. The isolates were preserved on nutrient agar (NA) slants and stored at 4 °C.
Sterility checks for sterilized explants used for endophyteisolation
This has been done by using following two methods.
(1) As per the method given by Pleban et al. (1995) surface sterilized plant tissues were imprinted onto nutrient media [16].
(2) The last rinsing water was cultured on the nutrient medium by using the method given by McInroy and Kloepper (1994)[17].
If no microbial growth occurs on the control petri-plate contains NA medium, surface sterilization is considered complete.
Morphological and biochemical identification of the endophytic bacteria
For observing the general colonial morphology, the strain was cultured on NA plates at 28±1 °C for 24 hrs. Macroscopic characteristics of the colony such as such as the shape, size, color, surface texture morphological the elevation, form and margin, were recorded by using the criteria described by Harley and Prescott (2007)[18].
Microscopy
Microscope (Olympus CH20BIMF200, Japan) at a magnification of 5X, 10X, 45X and 100X. Was employed to capture images. Bacteria were also subjected for scanning electron microscope (SEM) (Ho et al. 1999)[19]. The specimens were first fixed with 2.5% glutaraldehyde inphosphate buffer (PBS, pH6.8) was carried out followed by incubation for more than 4 h in room temperature. The specimens were dehydrated by a graded series of ethanol (50, 70, 80, 90 and 95%, 100) for about10 min at each step of ethanol for every 10 min and followed by 100% ethanol for 20 min. The cells were substituted with 100% acetone for 20 min and then freeze dried and coated with gold–palladium and were examined with a scanning electron microscope at different magnification under a SEM (Jeol, JSM-6390LV, Japan) at an accelerating voltage of 5 kV.
DNA extraction, PCR amplification, cloning and DNA sequencing of endophytic bacteria isolate KC1
For DNA extraction, PCR amplification, cloning and DNA sequencing from the DNA of isolate KC1, were cultured in 500 ml Erlenmeyer flasks containing 100 ml of nutrient broth with 120 rpm for 24 hrs at 28±1 °C. The bacterial mass was harvested by centrifugation. DNA was extracted from cultured bacteria by using a Takara Genome DNA Extraction Kit (Takara, Dalian, China) according to the manufactures’ specifications. Polymerase chain reaction (PCR) amplification and sequencing of isolated 16s rRNA gene was carried out using a Takara 16s rDNA bacterial Identification kit. Five microliters (5 μl) of the extracts DNA was amplified with primers 704 Fand 907R, for generation of a PCR product corresponding to nucleotide positions 27 to 1492 of the Escherichia coli 16S rDNA sequence. All reactions were carried out in 50 ml volumes, containing 12.5 p mol of each primer, 200 mM of each dNTP, 2.5 ml of 103 PCR buffer (100 mMTris-HCl, 15 mMMgCl2, 500 mM KCl; pH 8.3), and 0.5 U of Taq DNA polymerase (Roche Diagnostics, Mannheim, Germany) and increased to 50 ml with sterile water. DNA amplification was performed for 30 cycles and the PCR cycle was set as initial denaturation 94 °C for 5 min, followed by cooling, denaturation 94 °C for 1 min, annealing at 55 °C for 1 min and final extension at 72 °C for 10 min. Five microliters (5 μl) of PCR products was visualized by electrophoresis in 1.2% (w/v) agarose gel and with ethidium bromide (0.5 mg/ml) staining. To verify the presence of appropriate sized amplicons, the PCR products were subjected to electrophoresis in 1.2% agarose gel according to standard methods.
Phylogenetic analysis
Isolate KC1 sequence of 16S rDNA obtained was subsequentlyused as query sequence to search similar equences from Genbank using the basic local alignment search tool (BLAST) at the national center for biotechnology information (NCBI) and percent homology scores was generated to identify bacteria. Bacteria with 16S rDNA sequences>98% similarity was considered to be of the same phylotype. Each 16S rDNA sequence was compared by using the BLAST alignment program with data available from Gen Bank at the National Institutes of Health. The computer alignment provides a list of matching organisms, ranked in order of similarity between the unknown sequence and the sequence of the corresponding organism from the database. The percentage and absolute number of matched base pairs from each BLAST match was reported. Bacterial 16S rDNA sequences were also aligned with near neighbor sequences using the Clustal W program and phylogenetic relationships were inferred using a maximum likelihood algorithm (Phylip package). Phylogenetic trees were constructed by the neighbour-joining method (Saitou and Nei, 1987) using the PHYLIP version 3.6 software package [20].
RESULTS AND DISCUSSION
The method used for surface sterilization of Beta vulgaris has been optimized. After two weeks of incubation at 28 °C,a bright red colour endophytic bacteria (isolate KC1) was isolated from the leave explants of Beta vulgaris L.(fig. 1 a&b). The physiological and biochemical characterization of bacterial endophyte has been done. Based on morphological and partial biochemical characteristics, isolate KC1 was found a motile, coccobaccilus, Gram negative bacterium with red colonies, which gave a catalase positive reaction as described in table 1.
Fig. 1: Endophytic bacteria isolate KC1 grown on B. vulgarisL. leaf after 8-10 days of incubated at 28 °C
Table 1: Morphological and biochemical characteristics of the endophytic isolate KC1
Morphological characteristics |
|
Parameters |
Observation |
Isolate |
KC1 |
Species identified as |
Serratiamarcescens |
Cell shape |
Coccobaccilus |
Gram staining |
Negative |
Colony |
Bright red colour |
Outer edge of colony |
Entire |
Elevation |
Umbonate |
Oxygen requirement |
Facultative anaerobes |
Spore stain |
- |
Motility |
+ |
| Note: Positive results: + Negative results: - |
| Biochemical characteristics |
| Extracellular Enzymes |
| Catalase |
| Urease |
| Lipase |
| Biochemical Tests |
| Indole |
| Oxidase |
| Citrate |
| Sugar Fermentation |
| Glucose |
| Sucrose |
| Lactose |
| Fructose |
| Mannose |
| Rhamnose |
| Gelatin Liquefaction |
The basic cellular morphologies of colonies of isolate KC1 in petriplate showed brightred colour smooth edged colonies. Light microscopic view of coccobaccilus, gram negative endophytic bacteria KC1 strain, Scanning electron microscope (SEM)showed that bacterium is coccobaccilus as shown in fig.2 (a), 2 (b) and 2 (c). As per above characteristics described below, isolate KC1 may be placed under species of Enterobacteriaceae. Further study found that this endophytic bacterias uperficially resembled Serratiamarcescens, Serratiarubidaea, these two kinds of species have ability of secreting complicatedred pigments into the media and S. marcescens produces a reddish-orange tripyrrole pigment called prodigiosin.
However, it is difficult to identify this kind of bacteria to species level accurately.

Fig. 2: (a) Morphological examination of isolate KC1 from Beta vulgaris L. grown on nutrient agarmedia in 11 cm (diameter)petri-plate for 16 h at 28 °C (b) Light microscopic view of isolate KC1 (Bar = 10 µm) (c) Scanning electron micrograph of KC1 bacterial isolates under 25,000X magnification
Therefore, molecular method was used for obtaining more taxonomic information. DNA was isolated from the culture (isolate KC1). Quality was evaluated on 1.2% agarose gel, a single band of high-molecular weight DNA has been observed. Fragment of 16S rDNA gene was amplified by PCR using 8F and 1492R from the above isolated DNA. A single discrete PCR amplicon band of 1500 bp was observed (fig.3). The PCR amplicon was purified and further process for the sequencing. Forward and Reverse DNA sequencing reaction of PCR amplicon was carried out with 704F and 907R primers. Consensus sequence of 1450 bp 16S rDNA gene was generated from forward and reverse sequence data using aligner software. The 16S rDNA gene sequence was used to carry out BLAST alignment search tool of NCBI genbankdatabase. Based on maximum identity score first fifteen sequences were selected and aligned using multiple alignment software program Clustal W. Distance matrix was generated using RDP database. The evolutionary history was inferred using the Neighbor-Joining method [21]. The bootstrap consensus tree inferred from 1000 replicates [22] is taken to represent the evolutionary history of the taxa analyzed [23]. Branches corresponding to partitions reproduced in less than 50% bootstrap replicates are collapsed. The percentage of replicate trees in which the associated taxa clustered together in the bootstrap test (1000 replicates) is shown next to the branches [23]. The evolutionary distances were computed using the Kimura 2-parameter method [23] and are in the units of the number of base substitutions per site. The analysis involved 16 nucleotide sequences. Codon positions included were 1st+2nd+3rd+Noncoding. All positions containing gaps and missing data were eliminated. There were a total of 1445 positions in the final dataset. TheEvolutionary analyses were conducted in MEGA 5[24]. In the light of the 16S rRNA genes sequences of isolateKC1and other 11 representative reference taxa, the NJtree revealed distinctly that endophytic bacterium KC1 fromB. vulgaris L. is as a member of the Serratiamarcescens (fig. 4)which is identical with the result of morphological identification. In the NJ tree, bactrialendophyte sp. KC1 formed a monophyletic clade with Serratiamarcescens strain VIT-PTS (GenBank Accession Number: KJ716445.1) with 100% bootstrap support.

Fig. 3: PCR amplification of single 1.5 kb of 16 S rDNA amplicon16S rDNA gene on an agarose gel (1.2%). Lane 1: 1.5kb DNA (16S rDNA amplicon); Lane 2: DNA marker (1kb ladder).

Fig. 4: Neighbor-joining tree of Bacterial endophyte species KC1based on 16S rRNA gene sequences. Confidence values lessthan 50% obtained from a 1,000-replicate bootstrap analysis are shown at the branch–nodes
The two methods used by three different scientists, mention above for validation of sterilization technique gave comparable results, the growth of microorganisms were found in control NA petri-plates were discarded, if no microbial growth occurs on the control NA petri-plates medium were used for this study therefore, so by using these two techniques we confirmed that this isolate is endophyte and not epiphyte. From different parts of B. vulgaris total seventeen strains of endophytic bacteria have been isolated and preserved. Isolate KC1 was only isolate which was able to secrete red pigments. Molecular techniques have been widely applied in identification ofendophyticbacteria[25]. It is difficult task to use traditional biochemical, morphological identification methods to identify the strains to the species level. As per the phylogenetic analysis of 16S rRNA gene sequences,isolate KC1 and Serratiamarcescenswere in the same terminal clade. Referring to the traditional morphological observation, isolate KC1 belonged to Serratiamarcescens. These bacterial pigments, may be prodigiosin, which is a promising potential textile and food colorants [26]. However, the safety of this strain and its products is unknown. More research should be carried out to ensure that the strain as a potential source of food and textile colorant is nontoxic and nonpathogenic.
The composition and bioactivity of the pigment produced by isolate KC1, Serratiamarcescens, is in progress and will be further studied and results for the same will be published thereafter.
ACKNOWLEDGMENT
The financial support by Maulana Azad National Fellowship, in the form of JRF (F1-17.1/2013-14/MANF-2013-14-MUS-JHA-21819/ (SA-III/website) to Ms Bushra Khanam is acknowledged. Facilities provided by sub-DIC Bioinformatics center of Dept. of Bioengineering, Birla Institute of Technology, Mesra, Ranchi, is gratefully acknowledged.
CONFLICT OF INTERESTS
Declared None
REFERENCES
- Azevedo JL, Maccheroni J, Pereira O, Ara WL. Endophytic microorganisms: a review on insect control and recent advances on tropical plants. Electron J Biotechnol 2001;3:40-65.
- Zhang HW, Song CY, Tan RX. Biology and chemistry of endophytes. Nat Prod Rep 2006;23:753-71.
- Bandara WM, Seneviratne G, Kulasooriya SA. Interactions among endophytic bacteria and fungi: effects and potentials. J Biosci 2006;31:645-50.
- Bills GF, Polishook JD. Microfungi from Carpinuscaroliniana. Can J Bot Canadian 1991;69:1477-82.
- Kushwaha K, Saini A, Saraswat P, Agarwal MK, Saxena J. Colorful world of microbes: carotenoids and their applications. Adv Biomater 2014;24:4615–24.
- Babu S, Shenolikar IS. Health and nutritional implications of food colours. Indian J Med Res 1995;102:245–9.
- Johnson EA, Schroeder WA. Microbial carotenoids. Adv Biochem Eng Biotechnol 1996;53:119–78.
- Gunasekaran S, Poorniammal R. Optimization of fermentation conditions for red pigment production from Penicilliumsp. under submerged cultivation. Afr J Biotechnol 2008;7:1894-8.
- Jiang Y, Li HB, Chen F, Hyde KD. Production potential of water-soluble Monascus red pigment by a newly isolated Penicillium sp. J Agr Sci Tech 2005;1:113-26.
- Strobel A. Endophytes as sources of bioactive products. Microbes Infect 2003;5:535–44.
- Melvyn G. Pigments of fungi (Macromycetes). Nat Prod Rep 2003;20:615–39.
- Pattnaik P, Roy U, Jain P. Biocolours: new generation additives for food. Indian Food Industry 1997;16:21-32.
- Hallmann J, Quadt-Hallmann A, Rodrıguez KR, Kloepper JW. Interactions between Meloidogyne incognita and endophytic bacteria in cotton and cucumber. J Soil Biol Biochem 1997;30:925-37.
- Suryanarayanan TS, Wiltlinger KS, Faeth HS. Endophytic fungi associated with cacti Arizona. Mycological Res 1998;109:635-9.
- Vega FE, Pava-Ripoll M, Buyer JS. Endophytic bacteria in Coffeaarabica L. J Basic Microbiol 2005;45:371–80.
- Pleban S, Ingel F, Chet I. Control of Rhizoctoniasolani and Sclerotiumrolfsiiin the greenhouse using endophytic Bacillus spp. Eur J Plant Pathol 1995;101:665-72.
- McInroy JA, Kloepper JW. Studies on indigenous endophytic bacteria of sweet cornand cotton. In: O’Gara F, Dowling DN, Boesten B. eds. Molecular ecology of rhizosphere microorganisms. Weinheim VC. Germany; 1994. p.19–28.
- Harley JP, Prescott L. Laboratory Exercises in Microbiology. Fourth Edition. McGraw-Hill; 1999.
- Ho WH, Ranghoo VM, Hyde KD, Hodgkiss IJ. Ultrastructural study in Annulatascus hongkongensiss pnov., a freshwater ascomycete. Mycologia 1999;91:885–92.
- Felsenstein J. Phylogensis inference package (PHYLIP), version 3.69. Department of genome sciences and Department of biology, university of Washington, seattle, WA, USA; 2008.
- Saitou N, Nei M. The neighbor-joining method: A new method for reconstructing phylogenetic trees. J Mol Evol 1987;4:406-25.
- Felsenstein J. Confidence limits on phylogenies: An approach using the bootstrap. J Mol Evol 1985;39:783-91.
- Kimura M. A simple method for estimating evolutionary rate of base substitutions through comparative studies of nucleotide sequences. J Mol Evol 1980;16:111-20.
- Tamura K, Peterson D, Peterson N, Stecher G, Nei M, Kumar S. MEGA5: molecular evolutionary genetics analysis using maximum likelihood, evolutionary distance, and maximum parsimony methods. J Mol Evol 2011;28:2731-9.
- Baayen RP, Bonants PJM, Verkley G. Nonpathogenic isolates of the citrus black spot fungus, Guignardiacitricarpa, identified as a cosmopolitan endophytes of woody plants, G. magniferae (Phylostidacapilalensis). Phytopathol 2002;92:4644-477.
- Sameer ASM, Kristian FN, Thomas OL, Jens CF, Anne SM, Ulf T. Exploring fungal biodiversity for the production of water soluble pigments as potential natural food colourants. Curr Opin Biotechnol 2005;16:231-8.